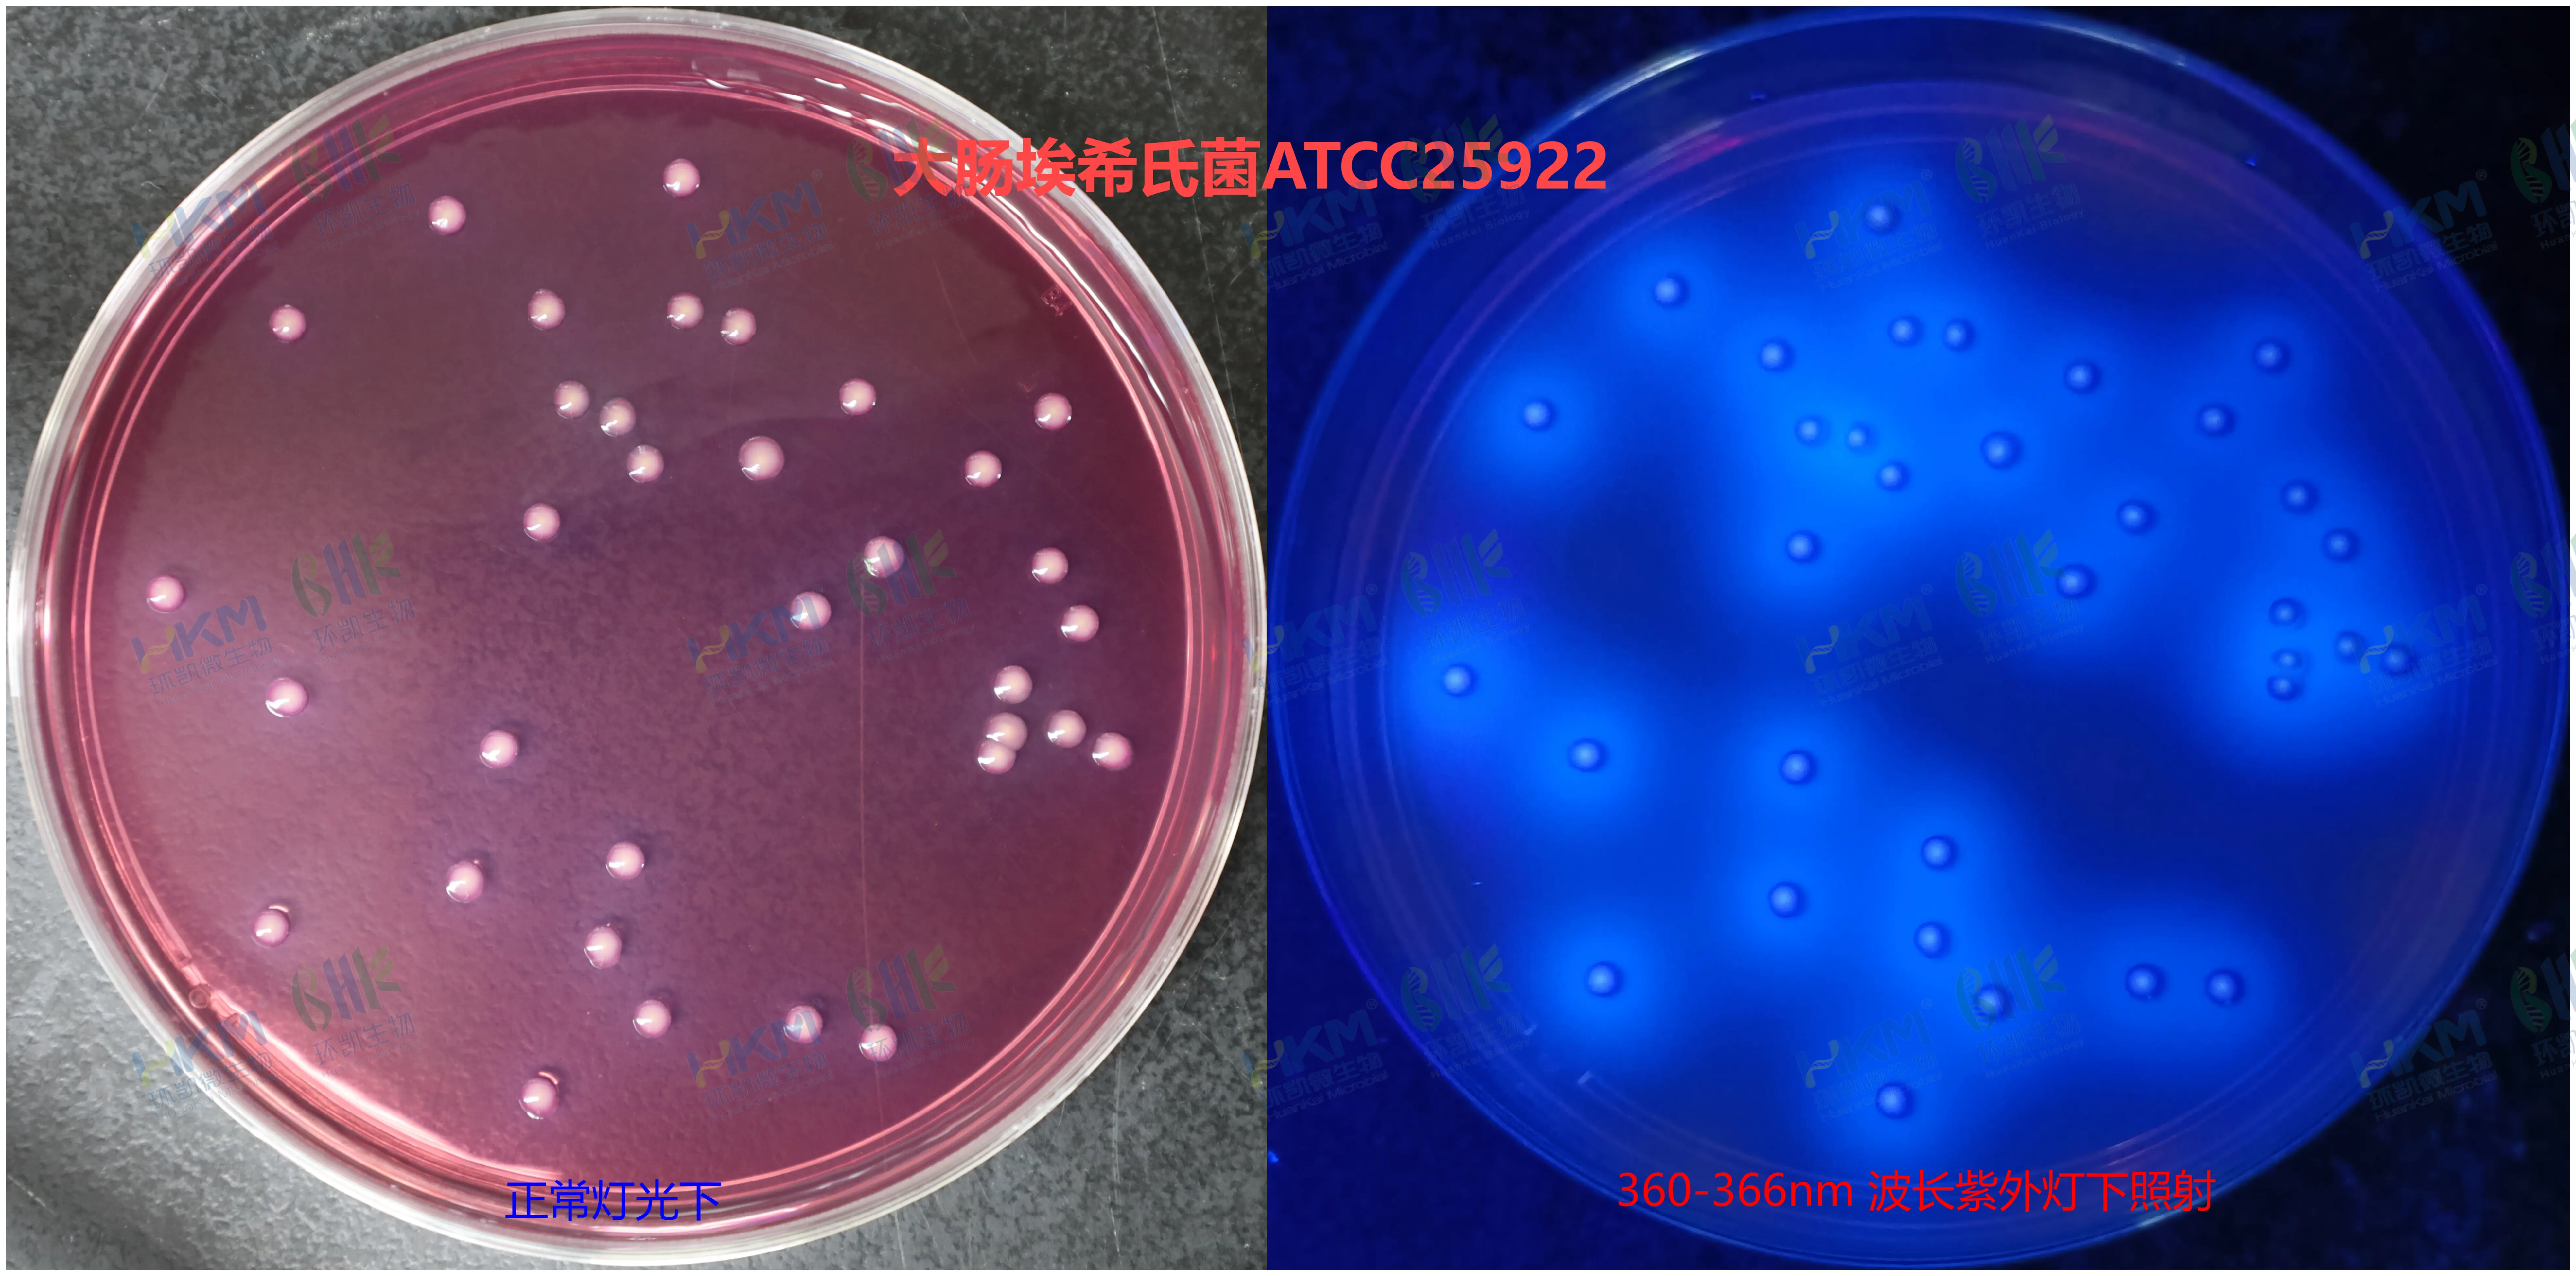
大肠埃希氏菌在结晶紫中性红胆盐MUG琼脂平板上的菌落特征

商品详细
说明书
微生物图册
行业应用
相关论文
产品名称:结晶紫中性红胆盐MUG琼脂平板
英文名称:Violet Red Bile MUG Agar Plate
其他叫法:VRBA-MUG平板培养基
产品编号与包装规格:
| 货号 | 产品类型 | 规格 |
|---|---|---|
| C22225B1 | 即用型成品平板 | 90mm×20个/盒 |
产品用途:用于水或食品中大肠埃希氏菌平板菌落计数。
配方成分:蛋白胨、酵母膏粉、乳糖、氯化钠、3号胆盐、中性红、琼脂、蒸馏水、结晶紫、MUG(即同类干粉 vrbamug培养基配方,最终pH 7.4±0.2)。
菌落特征:大肠埃希氏菌落为红色或紫红色、周围可有红色沉淀环。在波长 360-366nm 波长紫外灯下照射,为蓝色荧光菌落。
注意事项:储存温度需保持恒定,避免温差过大;如存放于冰箱中,不能靠近冰箱冷凝管和风扇直吹位置,以防培养基冻融或萎缩。
储存条件及保质期:2-8℃,避光保存,有效期见产品标签。
VRBA-MUG平板培养基(结晶紫中性红胆盐MUG琼脂) 更多产品资料详见 同类干粉培养基:022225 结晶紫中性红胆盐MUG琼脂培养基(VRBA-MUG) 100g/瓶。⬇️














